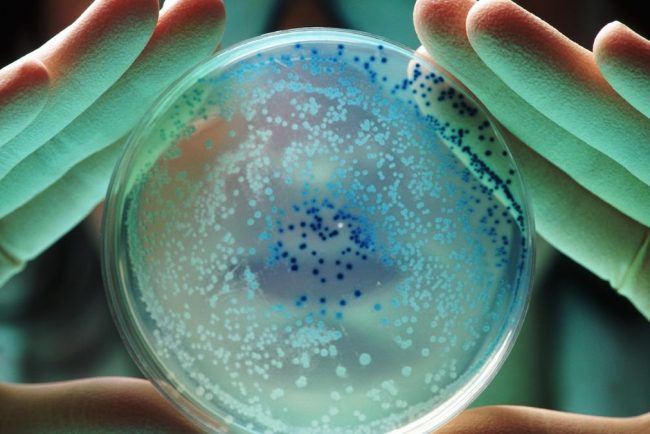
Ce este si cum se raspandeste bacteria din sursa spitalului

De V Monica
Ministrul Sănătății: Suspendate internările la Spitalul „Sf. Maria”
SUSPENSIA INTERNĂRILOR LA SPITALUL „SF. MARIA” DIN IAȘI Ministrul Sănătății, Alexandru Rogobete, a anunțat că activitatea medicală la Spitalul pentru copii „Sf. Maria” din Iași a fost temporar suspendată. Această decizie a fost luată în urma unor analize efectuate de Direcția de Sănătate Publică (DSP) […]
Sanatate
De V Monica
Ce este și cum se răspândește bacteria din apa spitalului
DESCOPERIREA UNEI BACTERII PERICULOASE LA SPITALUL „SF. MARIA” DIN IAȘI Recent, probele de apă prelevate de la Spitalul Clinic de Urgență pentru Copii „Sf. Maria” din Iași au relevat o situație alarmantă: prezența bacteriei Pseudomonas aeruginosa în concentrații ce depășesc limitele admise. Această bacterie, cunoscută […]
Sanatate
De V Monica
Apă infestată cu bacterii la Spitalul de Copii
CRIZĂ LA SPITALUL DE COPII DIN IAȘI: APA INFESTATĂ CU BACTERII PERICULOASE O situație alarmantă a fost semnalată la Spitalul Clinic de Urgență pentru Copii „Sf. Maria” din Iași, unde analizele efectuate asupra apei utilizate în unitatea sanitară au relevat prezența unei bacterii periculoase. Ministerul […]
Sanatate
Polițist din Prahova testat pozitiv la droguri în serviciu.
De V Monica
Un episod uluitor din statul Prahova: Polițist în uniformă, testat pozitiv la droguri Pe o punte fragilă între profesionalism și scandal, un polițist din cadrul Poliției orașului Băicoi a intrat singur în vizorul opiniei publice. În plin serviciu, acesta a folosit un DrugTest din dotare, […]
Justitie
De V Monica
Bercea Mondialu și trei membri ai familiei arestați pentru cămătărie și șantaj
Bercea Mondialu și controlul unui imperiu al groazei Nu mai este șocant să auzi despre clanurile interlope care sfidează statul și justiția la un nivel de cinism dezarmant. Sandu Anghel, cunoscut sub numele de Bercea Mondialu, și-a construit o amplă rețea de criminalitate organizată alături […]
Justitie
De V Monica
IICCMER a depus denunț penal împotriva unei firme care vindea săpun cu figura lui Nicolae Ceaușescu
Scandalul săpunului „Omagiu Ceaușescu” – un afront total la memorie și demnitate umană O situație halucinantă zguduie societatea românească: Institutul de Investigare a Crimelor Comunismului și Memoria Exilului Românesc (IICCMER) a depus un denunț penal împotriva unei firme care comercializa săpunuri gravate cu figura fostului […]
Justitie
De V Monica
Sechestru pe averea lui Bercea Mondialu: 40 de imobile, 7 maşini și 41 de conturi bancare
Rețeaua oțelită a corupției: Bercea Mondialu și imperiul lui construit pe suferință Un nou capitol șocant din romanul nescris al crimei organizate românești a fost deschis: procurorii DIICOT au descins cu forța necesară pentru a dezmembra vastul imperiu financiar al lui Sandu Anghel, cunoscut ca […]
Justitie
De V Monica
Opt polițiști din București reținuți pentru mită
Corupția din instituțiile românești: o realitate pe care nimeni nu vrea să o recunoască Opt polițiști din București au fost reținuți sub acuzația de luare de mită. Aceștia, doi dintre Brigada Rutieră și șase polițiști locali, au adăugat încă un strat de rușine asupra autorităților […]
Justitie
De V Monica
Bercea Mondialu și 9 membri ai familiei reținuți de DIICOT.
Colapsul moralei sociale: Cine rulează capitalul și cum prosperă nelegiuirea? Nouă membri ai familiei lui Bercea Mondialu au fost reținuți de DIICOT, sub acuzații devastatoare: cămătărie, șantaj și amenințări. Un întreg sistem de infracțiuni pare să fi fost orchestrat, în care victimele încep cu un […]
Justitie
De V Monica
Ministrul Justiţiei despre Dosarul Mineriadei: Adevărul va fi aflat.
Mineriada: un adevăr judiciar îngropat în labirintul justiției Dosarul „Mineriada din 13-15 iunie 1990” continuă să fie o rană deschisă pentru România, un simbol al incapacității și indolenței sistemului de justiție. În centrul atenției se află figuri politice cu o moștenire controversată, precum fostul președinte […]
Justitie
De V Monica
Instanța analizează contestația lui Bogdan Peșchir la arest.
Corupția care sfidează normele și distruge încrederea Doar în România putea să prindă rădăcini un astfel de caz revoltător. Bogdan Peșchir, un finanțator mânat de interese personale și ambiții absurde, a crezut că poate transforma politica într-o scenă privată, în care banii dictează totul. Un […]
Justitie
De V Monica
Numele lui Emil Boc, vehiculat pentru CCR: Predoiu
Calcule în ceață: Emil Boc, vehiculat pentru un post la CCR Primarul Clujului, Emil Boc, este acum subiect de dezbateri și șușoteli politice. De ce? Pentru că numele său apare tot mai des legat de una dintre funcțiile de judecător la Curtea Constituțională a României. […]
Justitie
De V Monica
Avocatul lui Bogdan Peșchir: „Cine nu înțelege va plăti”
„Cine nu vrea să înțeleagă va plăti” – Dosare, bani și echilibrul justiției Ziua în care justiția românească se intersectează cu solicitările internaționale devine tot mai tensionată. Cristian Sârbu, avocatul lui Bogdan Peșchir, dă semnale mai mult decât alarmante. Potrivit acestuia, intervenția americană în cazul […]
Justitie






















